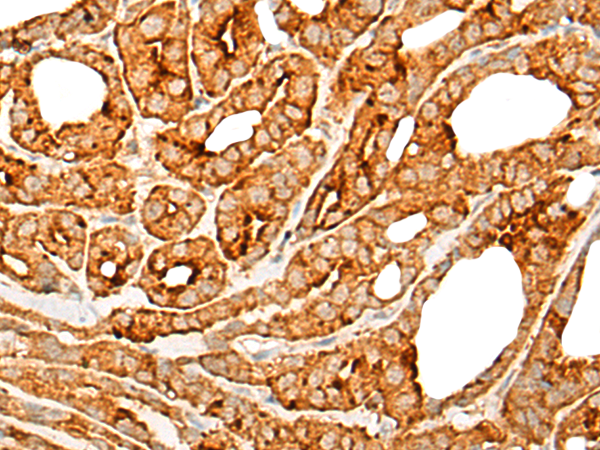

中文名稱:兔抗CNR1多克隆抗體
|
Background: |
This gene encodes one of two cannabinoid receptors. The cannabinoids, principally delta-9-tetrahydrocannabinol and synthetic analogs, are psychoactive ingredients of marijuana. The cannabinoid receptors are members of the guanine-nucleotide-binding protein (G-protein) coupled receptor family, which inhibit adenylate cyclase activity in a dose-dependent, stereoselective and pertussis toxin-sensitive manner. The two receptors have been found to be involved in the cannabinoid-induced CNS effects (including alterations in mood and cognition) experienced by users of marijuana. Multiple transcript variants encoding two different protein isoforms have been described for this gene. |
|
Applications: |
ELISA, IHC |
|
Name of antibody: |
CNR1 |
|
Immunogen: |
Synthetic peptide of human CNR1 |
|
Full name: |
cannabinoid receptor 1 |
|
Synonyms: |
CB1; CNR; CB-R; CB1A; CB1R; CANN6; CB1K5 |
|
SwissProt: |
P21554 |
|
ELISA Recommended dilution: |
5000-10000 |
|
IHC positive control: |
Human thyroid cancer and Human liver cancer |
|
IHC Recommend dilution: |
25-100 |

購物車
購物車 幫助
幫助
 021-54845833/15800441009
021-54845833/15800441009
